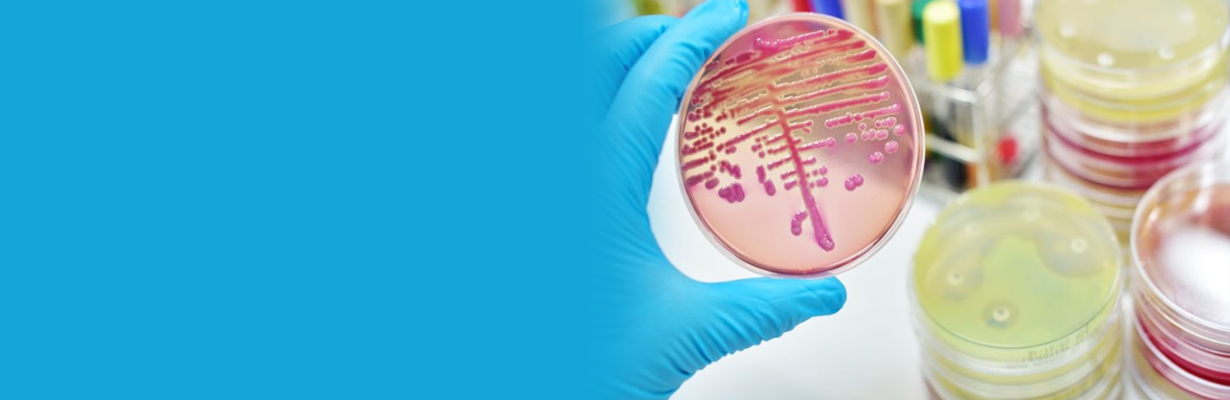
What are the important points to be considered in sepsis and septic shock?

Dr. Rajesh Chawla
Dr. Rajesh Chawla
What are the important points to be considered in sepsis and septic shock?
Dr. Rajesh Chawla, Senior Consultant, Institutes of Critical Care Respiratory and Sleep Medicine, Indraprastha Apollo Hospitals, New Delhi, will discuss the important points to be considered in sepsis and septic shock, in this video. Sepsis is defined as dysregulated organ dysfunction due to infection. He will explain if a sepsis patient develops shock or hypotension which does not respond to initial fluid therapy is known as a septic shock. He will further explain that airways or intubation has to be maintained along with blood pressure.

Dr. Rajesh Chawla
MBBS, MD, FCCM, EDIC, EDARM, FCCP, Specialized in Critical care, Pulmonary and Sleep disorders. Practices in Indraprastha Apollo Hospitals, New Delhi. Fellowships: Fellow of Indian college of Critical care medicine (USA), Fellow of American college of chest physicians (USA). Member of National College of Chest Physicians Practicing Critical care for the last 20 years President of Indian Society of Critical Care Medicine 2010-2012 President citation award, Society of Critical Care Medicine, USA.






.jpg)










Please login to comment on this article